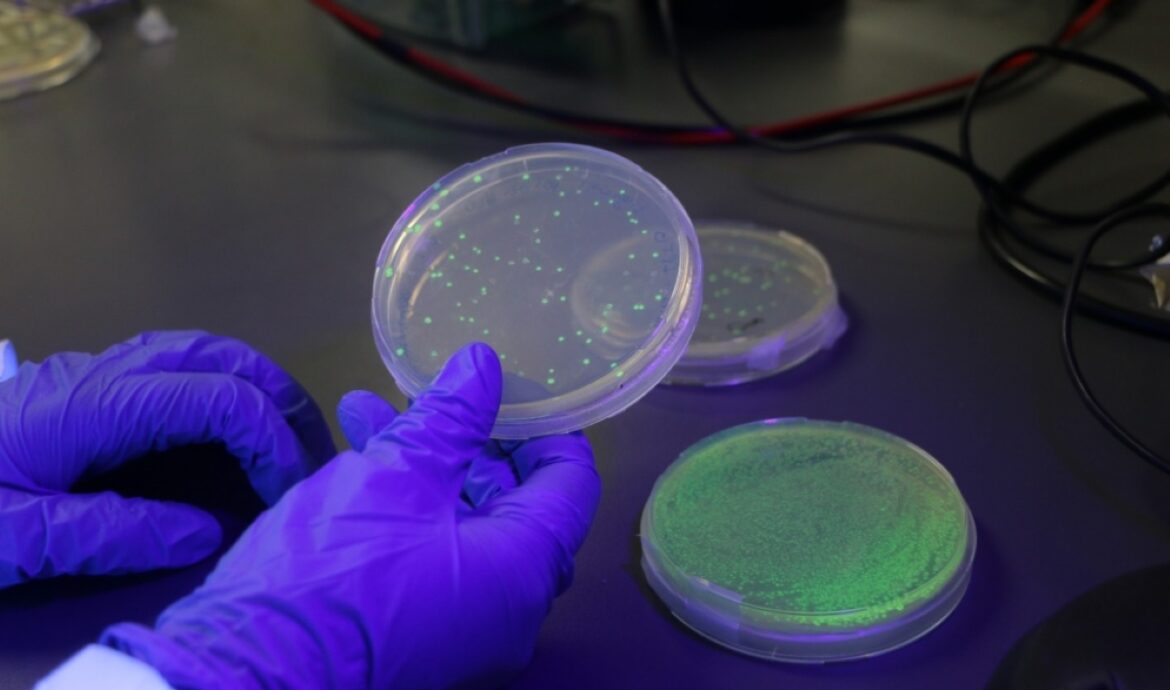

Estudiantes de la UNSE ganaron una competencia nacional de Agrimensura
NoticiasEn el marco del 12° Encuentro Nacional de Estudiantes de Agrimensura que se desarrolló en Catamarca, la delegación de estudiantes de agrimensura de la UNSE obtuvo importantes premios.

INTA, UNSE y UNLP presentaron tecnología de avanzada para medición forestal
NoticiasSe presentó una herramienta innovadora para la medición de la estructura forestal mediante tecnología LiDAR a través de una jornada de trabajo en el Campo Experimental del INTA Santiago del Estero, de la que participó un equipo multidisciplinario e interinstitucional de investigadores.

Aceite esencial obtenido del aguaribay puede ser usado para combatir bacterias e insectos en alimentos
NoticiasUn grupo de científicos de la UNSE y el CONICET, desarrollan el proyecto denominado “Aplicaciones biotecnológicas del aceite esencial obtenido del aguaribay”.
Crean test para detectar glifosato en alimentos y bebidas
NoticiasInvestigadores de la UNSE elaboraron un test para detectar glifosatos en alimentos y bebidas.

PREMIAN EL DESARROLLO DE ALIMENTOS DE SOJA SALUDABLES PENSADO PARA POBLACIÓN VULNERABLE
NoticiasLa Asociación de la Cadena de Soja de Argentina (ACSOJA) reconoció este estudio conjunto entre Conicet, UNT, EEAOC y UNSE.

El “supersnack saludable” a base de zapallo y zanahora
NoticiasUn equipo del CONICET NOA Sur en Santiago del Estero desarrolla un producto a base de zapallo y/o zanahoria, que además de poseer sabor y textura particulares, se caracteriza por ser una importante fuente de fibras, minerales, vitaminas y compuestos antioxidantes.

UNA ANTOLOGÍA DE POETAS DEL NOROESTE ARGENTINO
Libros SíLo publicó la editorial de la Universidad Nacional de Santiago del Estero y se enmarca en los festejos por el 50ª aniversario de la UNSE. Una compilación de Alfonso Nassif. Hace pocas semanas, la Editorial de la Universidad Nacional de Santiago del Estero realizó la presentación del libro ANTOLOGÍA DE POETAS DEL NOROESTE ARGENTINO, una

UNSE Y UBA, SEDES DEL DEBATE PRESIDENCIAL 2023
NoticiasEl primer debate se realizará el 1 de octubre en la Universidad Nacional de Santiago del Estero, que utilizará al efecto el Fórum de la capital; el segundo será una semana después en la Facultad de Derecho de la Universidad de Buenos Aires. La Cámara Nacional Electoral se reunió ayer en el Tribunal con los

LA UNER Y LA UNSE TAMBIÉN CELEBRARON SUS PRIMEROS 50 AÑOS
NoticiasLas universidades nacionales de Entre Ríos y Santiago del Estero conmemoraron su primer medio siglo de vida con actos, homenajes y más celebraciones. Festejos que representan la federalización de la educación superior en Argentina. Mayo tiene varias celebraciones universitarias. A los festejos de la Universidad Nacional de San Luis, se suman también los 50 años

La UNSE celebra a su primer egresado de la Licenciatura en Gestión Universitaria
NoticiasSe trata de René Montoya. La carrera se cursa en la Facultad de Humanidades, Ciencias Sociales y de la Salud de la Universidad Nacional de Santiago del Estero. La Licenciatura en Gestión Universitaria, espacio de formación impulsado desde la Facultad de Humanidades, Ciencias Sociales y de la Salud de la Unse, vivió un momento histórico

Se replicará el modelo de fábrica de baterías de litio UNLP en Santiago del Estero
NoticiasLa provincia de Santiago del Estero, YPF, UNLP, Y-TEC, la UNSE y el Centro de Investigación y Desarrollo
provincial (CIID) acordaron la creación de un consorcio que potenciará a la región del norte argentino.

La UNSE prepara para 2023 la “II Jornada Regional del Arsénico”
NoticiasSerá el próximo 31 de marzo de 2023, en el Día Nacional del Agua. Autoridades de la Mesa Interinstitucional del Arsénico de Santiago del Estero brindaron detalles del evento que lleva el lema: “Avances, desafíos y experiencias en el abordaje de la problemática del arsénico”. La Universidad Nacional de Santiago del Estero anunció la realización









